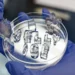
Quand la "glace en gelée" réutilisable garde les choses froides - sans fondre

Benjamin Brigaud, Université Paris-Saclay
La géothermie évoque généralement la production de chaleur, mais elle peut également rafraîchir ou produire du froid. Et cela de manière beaucoup plus économe que les climatiseurs classiques et avec un impact écologique réduit. Non seulement il s’agit d’une solution bas carbone, mais elle ne rejette pas de chaleur dans l’air extérieur et ne contribue donc pas à l’effet d’îlot de chaleur urbain, à l’origine de la surchauffe des villes en période de canicule.
La vague de chaleur de fin juin et de début juillet 2025, où 38 °C ont été mesurés à Paris, rappelle que le refroidissement des bâtiments sera un enjeu crucial pour le confort et la sécurité de leurs occupants dans les prochaines années et décennies. Cela fait les beaux jours de la climatisation : en France, la fraction des ménages possédant un climatiseur est passée de 5 % en 2005 à 25 % en 2020.
Mais se tourner vers les climatiseurs pour refroidir nos bâtiments pose question : ces appareils consomment beaucoup d’électricité.
À l’échelle mondiale, le refroidissement représentait, en 2016, 18,5 % de la consommation totale d’électricité dans les bâtiments, contre 13 % seulement en 1990. L’Agence internationale de l’énergie (AIE) table d’ailleurs sur une forte augmentation du nombre de climatiseurs à l’échelle mondiale, avec un taux d’équipement des ménages qui devrait passer de 30 % en 2016 à plus de 60 % en 2050. Elle anticipe également que la climatisation pourrait devenir l’un des principaux contributeurs de la demande mondiale d’électricité dans les prochaines décennies.
L’autre inconvénient des climatiseurs est que, pour produire du froid, ils rejettent de la chaleur à l’extérieur – ce qui contribue localement à la surchauffe urbaine.
À titre d’exemple, à Paris, les climatiseurs sont typiquement de petits équipements de ce type, de 6 à 70 kW par unité. Il a été démontré que leur utilisation pourrait augmenter de 0,5 à 2 °C la température à Paris en été, amplifiant ainsi l’effet d’îlot de chaleur urbain bien connu dans les villes. Lors des vagues de chaleur, ce microclimat sera d’autant plus exacerbé que le nombre de canicules par an va augmenter dans le futur, passant de neuf recensés à Paris entre 1960 et 1990 où la température maximale a atteint 38 °C, à potentiellement une par an à l’horizon 2100.
Une solution pour refroidir les bâtiments sans surchauffer l’air extérieur alentour serait de mobiliser la fraîcheur de notre sous-sol. La géothermie représente ainsi une piste sérieuse non seulement pour le chauffage à la saison froide, mais également pour le confort d’été.
Une solution économique qui ne génère pas d’îlot de chaleur
À quelques mètres de profondeur, en France, le sous-sol se trouve à une température constante de 12 °C toute l’année. Puis en moyenne, la température augmente en fonction de la profondeur, d’environ 3,5 °C tous les 100 mètres. À 100 mètres de profondeur, cette température est donc de 15/16 °C, et à 200 mètres de profondeur, elle est d’environ 20 °C. À moins de 200 mètres, le sous-sol représente donc une source de fraîcheur, si on vise une température inférieure à 20 °C.
Cette fraîcheur est abondante, mobilisable quasiment partout sur notre territoire, et peut être ainsi produite localement. C’est une solution de refroidissement bas carbone et économe, non intermittente et quasiment inépuisable. La solution serait donc de mieux utiliser cette source de fraîcheur en été, et inversement, de chaleur en hiver.
Mobiliser la fraîcheur du sous-sol pour produire du froid et rafraîchir les bâtiments est une solution technique mature, déjà déployée un peu partout dans le monde. Elle consiste à transférer des calories du sous-sol aux bâtiments par l’intermédiaire d’un ou plusieurs forages de quelques mètres à une centaine de mètres de profondeur, alimentant une pompe à chaleur géothermique (PACg). Cette géothermie est appelée « géothermie de surface », avec des forages d’une profondeur inférieure à 200 mètres.
Comment fonctionne une pompe à chaleur géothermique ?
À l’heure actuelle, cette technologie est surtout utilisée pour le chauffage. Pourtant, si la PACg est réversible, elle permet également de produire du froid en été. Or, ce type de pompe à chaleur (PAC) est pour l’instant utilisée de manière négligeable en France.
Pour le chauffage par PACg, relevant de la géothermie de surface classique, deux techniques sont principalement mises en œuvre.
La première (illustration de droite sur le schéma ci-contre) consiste à capter de l’eau souterraine à environ 12 à 15 °C pour produire du chaud. Comme des calories sont prélevées dans cette eau pour le chauffage, de l’eau plus froide (d’une température comprise entre 5 et 10 °C) est alors réinjectée à la même profondeur dans un autre forage localisé à plusieurs dizaines de mètres. On parle alors de doublet géothermique sur nappe phréatique, c’est-à-dire utilisant l’eau souterraine.
La deuxième technique (illustration de gauche sur le schéma ci-dessus) est celle de la PACg sur sonde géothermique verticale. Elle consiste à placer dans un trou de forage, à une profondeur de quelques mètres à une centaine de mètres, une sonde géothermique. Celle-ci est généralement constituée d’un tube en U en polyéthylène haute densité et contenant un fluide caloporteur constitué d’eau glycolée. Comme le fluide caloporteur est réinjecté à une température d’environ 0 °C, le sous-sol se refroidit de quelques degrés en profondeur, typiquement de 3 °C à 1 mètre du forage, ce qui reste suffisant pour réchauffer le fluide caloporteur qui alimente la PACg.
Les deux techniques permettent toutes deux d’alimenter une PACg, dont le coefficient de performance (COP) est généralement de 4 à 5. C’est-à-dire que pour 1 kWh d’électricité consommé par la PACg, 4 à 5 kWh de chaud ou de froid seront restitués. C’est beaucoup plus efficace que de capter l’air chaud extérieur pour alimenter une PAC aérothermique (PACa) – c’est-à-dire, fonctionnant à l’air – pour produire du froid. De plus, la chaleur émise par la PACg est injectée dans le sous-sol, et non dans l’air extérieur comme avec une PACa, évitant de créer des îlots de chaleur urbains (ICU).
Une autre technique est celle du « géocooling ». La fraîcheur du sous-sol est alors directement utilisée dans les réseaux de ventilation et de refroidissement du bâtiment (plancher/plafond rafraîchissant, ventilo-convecteur, centrale de traitement de l’air…), sans alimenter de PACg. Il s’agit alors d’un rafraîchissement dit passif dans la mesure où il ne consomme quasiment pas d’électricité, hormis les pompes de circulation du fluide caloporteur dans le sous-sol et le bâtiment. Il se caractérise par des coefficients de performance imbattables : de 30 à 50 ! C’est-à-dire, pour 1 kWh consommé, 30 à 50 kWh de fraîcheur peuvent être restitués.
Stocker de la chaleur dans le sous-sol pour l’hiver
Un autre avantage de la géothermie pour le refroidissement des bâtiments est que la chaleur évacuée dans le sous-sol en été par la PACg peut être bien utile quelques mois plus tard, à la saison froide. En effet, cela permet de réchauffer localement le sous-sol de quelques degrés autour des sondes, ou encore de réinjecter de l’eau plus chaude (jusqu’à 25 °C) directement dans l’aquifère, ce qui permet de stocker de la chaleur.
Comme il s’agit d’une pompe à chaleur réversible, on peut inverser le système entre l’été et l’hiver. On peut alors « récupérer » en été les calories perdues en hiver, ce qui permet d’augmenter le rendement annuel de l’installation géothermique.
Ce stockage de chaleur peut encore être amplifié par l’ajout de ressources supplémentaires, comme des panneaux solaires thermiques (l’eau chauffée peut être directement réinjectée dans les puits) ou photovoltaïques (l’électricité produite en excès la journée en été alimente alors une résistance qui chauffe de l’eau). Dans le cas de bâtiments industriels, on peut aussi récupérer la chaleur dite fatale, produite par les procédés industriels (par exemple, par les data centers) pour chauffer l’eau réinjectée dans les puits.
Il s’agit donc de réchauffer le sous-sol de manière active, soit en réinjectant l’eau chaude (à environ 40-50 °C) directement dans la nappe phréatique, soit dans le sous-sol via les sondes géothermiques. Cette géothermie « réversible », avec un couplage du chauffage en hiver et rafraîchissement en été, est le grand avantage de cette ressource, d’autant plus que ce couplage permet l’optimisation des systèmes de chauffage et de rafraîchissement.
Ambitions politiques et potentiel inexploité
Invité le 29 juin 2025 lors du Grand Jury RTL-Le Figaro-Public Sénat-M6, le premier ministre François Bayrou a rappelé que la géothermie permet de rafraîchir en économisant plus de 90 % de l’électricité. Lorsqu’il était haut-commissaire au plan, il avait lui-même reconnu l’intérêt de développer la géothermie de surface (à moins de 200 mètres de profondeur) pour chauffer et refroidir des bâtiments. https://www.youtube.com/embed/_JXhSOxHGIA?wmode=transparent&start=0 François Bayrou, premier ministre, invité du Grand Jury RTL-Le Figaro-Public Sénat-M6, le 29 juin 2025 (passage à 00:37:00).
Lors de sa visite au centre opérationnel de gestion des crises du ministère de l’intérieur le 1er juillet 2025, la ministre de la transition écologique Agnès Pannier-Runacher rappelait l’enjeu à rafraîchir sans renvoyer de la chaleur à l’extérieur.
Malgré son potentiel, la géothermie pour le chauffage (hors production d’électricité) n’a produit qu’un million de térajoules (TJ) en 2020, soit seulement 0,17 % de la production annuelle mondiale d’énergie, qui s’élevait à 580 millions de TJ. En France, la géothermie a produit 7 térawattheures (TWh) de chaleur en 2023 : 2,3 TWh pour la géothermie profonde et 4,7 TWh pour la géothermie de surface (utilisée pour les PACg)… soit 0,49 % des 1 420 TWh d’énergie produite en France en 2023.
Dans notre pays, les PACg ne représentent aujourd’hui que 2 % du parc des PAC. Le coût de leur installation peut être un frein : il représente le double de celui d’une chaudière à gaz. Mais une fois amorti, leur coût de fonctionnement est très faible, et même inférieur au coût d’exploitation d’une pompe à chaleur à air (PACa).
L’installation d’une PACg peut également s’avérer complexe, car elle nécessite de forer le sous-sol avant de mettre en place le système de chauffage et climatisation. Peu de professionnels maîtrisent cette technologie ou la proposent spontanément, elle est souvent mise en œuvre à l’initiative du propriétaire.
Il y a un vrai sujet sur comment développer la géothermie et la rendre plus incitative. Nul doute que les prochaines années seront charnières pour mieux développer la filière. Le 28 juillet 2025, le ministère de l’économie a présenté ses sept mesures pour accélérer le développement d’une énergie renouvelable et locale. Par exemple, simplifier les démarches administratives et améliorer la communication sur la géothermie.
Une autre des mesures vise également à réduire les délais de confidentialité de certaines données d’explorations géologiques : aujourd’hui, les entreprises qui font des forages pour étudier le sous-sol doivent garder leurs résultats confidentiels pendant 10 ans. Cela permettrait de les valoriser plus rapidement pour lancer de nouveaux projets de géothermie tout en réduisant les coûts d’exploitation.
Benjamin Brigaud, Professeur en géologie et géothermie, Université Paris-Saclay
Cet article est republié à partir de The Conversation sous licence Creative Commons. Lire l’article original.
Newsletter Enerzine
Recevez les meilleurs articles
Énergie, environnement, innovation, science : l’essentiel directement dans votre boîte mail.